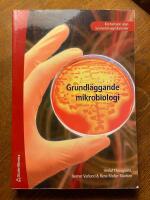
Grundl&auml;ggande mikrobiologi - - kortversion

-

Lärares lärande
Häftad bok. Studentlitteratur AB. 1 uppl. 1994. 335 sidor.
Gott skick. Några överstrykningar med gul penna i den senare delen av boken. Inget namn. Kom ihåg! Portot gäller oavsett hur många böcker eller tidningar du köper från oss; Anthon Klipp & Konsult här på Bokbörsen. … läs mer
Inrikes enhetsfrakt Sverige: 62 SEK- ISBN
- 9789144348216
- Titel
- Lärares lärande
- Författare
- Björn Beckman - Ann-Katrin Bäcklund - Mats Ekholm - Peter Emsheimer - Rolf Lander - Torsten Madsén - Ingegärd Sandström Madsén
- Förlag
- Studentlitteratur AB
- Utgivningsår
- 1994
- Omfång
- 335 sidor
- Bandtyp
- Häftad
- Vikt
- 500 g
- Språk
- Svenska
- Baksidestext
- Samhällsförändringarna leder till stora krav på utveckling av skolans verksamhet. Skolan ska förbereda för ett livslångt lärande samtidigt som alla elever får en kvalificerad yrkesutbildning. Om detta mål ska kunna uppnås måste lärarnas kompetens stå i centrum för den långsiktiga utvecklingen av skolan. I denna bok, som ger en översikt över forskning och praktiska erfarenheter rörande skolutveckling och lärares kompetensutveckling, tas bland annat följande frågor upp till diskussion:
Hur kan skolan bli en lärande organisation?
Vilka är betingelserna för lärares eget lärande?
När och hur utvecklar lärare sin kompetens?
Hur kan förutsättningarna för lärares eget lärande förbättras?
Den nationella utvecklingsplanen för skolväsendet betonar att skolan måste utvecklas till en lärande organisation.
Läs mer om boken på studentlitteratur.se
Studentlitteratur AB 1 9789144348216 -

I sagans land : klassiska folksagor och ävent...
Inbunden bok. Bokförlaget Semic. 2015. 112 sidor.
Mycket gott skick. Skyddsomslag i mycket gott skick.
Inrikes enhetsfrakt Sverige: 62 SEK- ISBN
- 9789155262167
- Titel
- I sagans land : klassiska folksagor och äventyr tecknade och berättade av Peter Madsen
- Författare
- Madsen, Peter
- Förlag
- Bokförlaget Semic
- Utgivningsår
- 2015
- Omfång
- 112 sidor
- Bandtyp
- Inbunden
- Mått
- 200 x 267 mm Ryggbredd 13 mm
- Vikt
- 545 g
- Språk
- Svenska
- Baksidestext
- Följ med in i sagans fantastiska värld! Möt Snövit och de sju dvärgarna, den tappre skräddaren, räven och de tre kungasönerna, Hans och Greta, isbjörnsprinsen, guldgåsen, Askungen, de tre bockarna bruse och många, många fler.Tecknaren Peter Madsen återberättar här några av våra mest klassiska och älskade sagor. Alla äventyr är rikt illustrerade med sagolikt vackra bilder.
Bokförlaget Semic 9789155262167 -
Grundläggande mikrobiologi - - kortversion
Häftad bok. Studentlitteratur AB. 1 uppl. 2007. 323 sidor.
Mycket gott skick.
Inrikes enhetsfrakt Sverige: 62 SEK- ISBN
- 9789144006215
- Titel
- Grundläggande mikrobiologi - - kortversion
- Författare
- Herluf Thougaard - Verner Varlund - Rene Møller Madsen
- Förlag
- Studentlitteratur AB
- Utgivningsår
- 2007
- Omfång
- 323 sidor
- Bandtyp
- Häftad
- Vikt
- 705 g
- Språk
- Svenska
- Baksidestext
- Boken ger en grundläggande förståelse för olika celltyper och deras funktion, mikroorganismer tillväxt, metabolism samt en presentation av bakteriesystematiken.
Förutom bakterier beskrivs svampar, virus, protozoer, alger och parasiter. Ett kapitel behandlar mikroorganismer hos människor och djur och ett annat beskriver genteknikens viktigaste principer.
Boken avslutas med praktiska laborationer samt ordförklaringar. Samtliga kapitel avslutas med repetitionsfrågor och till vissa kapitel hör även fallbeskrivningar.
Boken är en översättning från danska och har anpassats efter svenska förhållanden. Den nya upplagan är uppdaterad och utökad främst med avseende på gentekniken och bakteriesystematiken.
Den här boken en kortversion av andra upplagan av Grundläggande mikrobiologi med livsmedelsapplikationer. Skillnaden består i att de livsmedelsrelaterade kapitlen har tagits bort. Kortversionen lämpar sig därför för introducerande högskole- och universitetskurser i ämnet utan livsmedelsanknytning. För livsmedelsutbildningar rekommenderar vi den fullständiga versionen (www.studentlitteratur.se/ 7449).
Studentlitteratur AB 1 9789144006215 -
 Inrikes enhetsfrakt Sverige: 62 SEK
Inrikes enhetsfrakt Sverige: 62 SEK- ISBN
- 9789120045030
- Titel
- Akvariefiskar i färg
- Författare
- Meulengracht-Madsen, Jens - Pinter, Helmut - Sørensen, Kjeld Warthoe
- Förlag
- Stockholm : AWE/Geber
- Utgivningsår
- 1976
- Språk
- Svenska
Stockholm : AWE/Geber 9789120045030 -

Korgpil och pilkorg i Skåne - material och hi...
Häftad bok. Hemslöjden i Malmöhus län. 1995. (2),83 sidor.
Mycket gott skick. Illustrationer. Klammerhäftad med tryckt omslag. Blekt rygg.
Inrikes enhetsfrakt Sverige: 62 SEK- ISBN
- 9789163031854
- Titel
- Korgpil och pilkorg i Skåne : material och historik
- Författare
- Munkstrup, Toly - Hemslöjden i Malmöhus län
- Förlag
- Landskrona : Hemslöjden i Malmöhus län
- Utgivningsår
- 1995
- Språk
- Svenska
Hemslöjden i Malmöhus län 9789163031854 -

Människor och makter i vikingarnas värld
Inbunden bok. Stockholm : Ordfront. 1998. 224 sidor.
Nära nyskick. Skyddsomslag i nära nyskick.
Inrikes enhetsfrakt Sverige: 62 SEK- ISBN
- 9789173245913
- Titel
- Människor och makter i vikingarnas värld
- Författare
- Steinsland, Gro - Meulengracht Sørensen, Preben - Hultgård, Anders - Sjöström, Hans O.
- Förlag
- Stockholm : Ordfront
- Utgivningsår
- 1998
- Språk
- Svenska
Stockholm : Ordfront 9789173245913 -

Bland tomtar och troll årg 115
Inbunden bok.
Nyskick. Upplev magin i Bland tomtar och troll med nya berättelser och klassiska sagor i en förtrollande samling! | Bokförlaget Semic, Utg. 2022 | Förlagsband. 8:o (168x194 mm) … läs mer
Inrikes enhetsfrakt Sverige: 62 SEK- ISBN
- 9789155270346
- Titel
- Bland tomtar och troll årg 115
- Författare
- Karlsson, Ylva
- Förlag
- Bokförlaget Semic
- Utgivningsår
- 2022
- Omfång
- 112 sidor
- Bandtyp
- Inbunden
- Mått
- 168 x 194 mm Ryggbredd 12 mm
- Vikt
- 355 g
- Språk
- Svenska
- Baksidestext
- ”Bland tomtar och troll” har i hela 115 år tagit oss med på spännande äventyr i sagornas värld. Låt dig förtrollas av fyra helt nyskrivna berättelser av Inger Edelfeldt, Ylva Karlsson, Johanna Nilsson och Daniel Edfeldt. Peter Madsen återberättar folksagan om fiskaren och hans fru och här finns även klassiska sagor illustrerade av de älskade mästarna Einar Norelius och John Bauer.
9789155270346 -

Trettio dagars mörker
Pocketbok.
Nyskick. En spännande och originell kriminalroman där en ensamstående författare utmanas att skriva en bok på trettio dagar. | Modernista, Utg. 2022 | Pocket. 8:o (110x178 mm) … läs mer
Inrikes enhetsfrakt Sverige: 62 SEK- ISBN
- 9789180234849
- Titel
- Trettio dagars mörker
- Författare
- Lund Madsen, Jenny
- Förlag
- Modernista
- Utgivningsår
- 2022
- Omfång
- 348 sidor
- Bandtyp
- Mått
- 110 x 178 mm Ryggbredd 22 mm
- Vikt
- 186 g
- Språk
- Svenska
- Baksidestext
- VINNARE AV HARALD MORGENSEN-PRISET FÖR ÅRETS BÄSTA DANSKA KRIMINALROMAN! »Så välskriven att det är svårt att släppa den.« Lotta Olsson, DN »Spännande till sista sidan. Årets mest originella kriminalroman.« Betyg: 5 av 6 - PolitikenDen snobbiga, ensamstående, alkoholiserade och dessutom skrivblockerade författaren Hannah får genom en ödets nyck utmaningen att skriva en kriminalroman på trettio dagar.
Hon reser hals över huvud till Island för inspiration och tar logi hos den gästfria Ella i den fridfulla lilla orten Húsafjörður. Men under den lugna ytan är starka strömmar i rörelse. Några dagar efter Hannahs ankomst fiskas Ellas systerson Thor livlös upp ur havet. Thor var, som alla andra på orten, son till en fiskare, men han led av stark vattenskräck och alla visste att han alltid undvek havet. Så hur kunde han ha drunknat? Var det verkligen en olycka? Hannah börjar undersöka dödsfallet som en möjlig ingång till sin klichédeckare, men dras snart in i byn Húsafjörður dunkla hemligheter.
I svensk översättning av Sabina Söderlund.JENNY LUND MADSEN är en dansk författare, född 1983. Hon har en magisterexamen i Filmvetenskap och har studerat manusförfattande på University of California i Los Angeles. Sedan 2009 har hon arbetat som manusförfattare för filmer och tv-serier. Trettio dagars mörker [2020] är hennes första deckare, som vann Harald Mogensen-priset för Årets bästa danska kriminalroman och därmed också är nominerad till det nordiska deckarpriset Glasnyckeln.»Man hålls på sträckbänken ända in i mål. Läs, njut och klura - du blir inte besviken!« Betyg: 5 av 5 - Bokprataren »Det mest underhållande jag läst på länge.« Läsa & Lyssna
9789180234849 -

Trollungarnas magiska natt
Inbunden bok.
Nyskick. Trollungarna firar mormor under fullmånen, men en mystisk sjukdom hotar. En magisk och humoristisk saga för barn. | Bokförlaget Semic, Utg. 2023 | Förlagsband. 4:o (200x270 mm) … läs mer
Inrikes enhetsfrakt Sverige: 62 SEK- ISBN
- 9789155272005
- Titel
- Trollungarnas magiska natt
- Författare
- Madsen, Peter
- Förlag
- Bokförlaget Semic
- Utgivningsår
- 2023
- Omfång
- 32 sidor
- Bandtyp
- Inbunden
- Mått
- 200 x 270 mm Ryggbredd 10 mm
- Vikt
- 321 g
- Språk
- Svenska
- Baksidestext
- I fullmånens sken händer vidunderliga ting när Trollungarnas familj beger sig ut för fira mormor med en stor fest. Men vad har hänt med lilla Suck? Och vilka av skogens varelser kan hjälpa till att göra honom frisk igen?Trollskogen är en sagolik serie böcker för de minsta, fylld med humor, dramatik och värme. Varje uppslag är illustrerat med levande och detaljrika bilder av Peter Madsen, känd från sin egen succéserie Valhall.
9789155272005 -

Marschkängan och andra nummer ur de militära...
Häftad bok. Andra uppl. 1941. 114 + 32 sidor.
Gott skick. 16 x 22 cm, 240 gram. Illustrerad med teckningar samt några svartvita foton. Postas inom ett dygn
Inrikes enhetsfrakt Sverige: 62 SEKAndra -

Valhall - Den samlade sagan 5
Inbunden bok.
Mycket gott skick. Utgiven av Apart Förlag 2015. Kartonnage. 213 sid. Samlingsvolym som innehåller albumen 13, 14, 15 - Balladen om Balder, Muren, Völvans syner. Lätt repig baksida. … läs mer
Inrikes enhetsfrakt Sverige: 62 SEK- ISBN
- 9789187877353
- Titel
- Valhall : den samlade sagan 5
- Författare
- Madsen, Peter
- Förlag
- Apart Förlag AB
- Utgivningsår
- 2015
- Omfång
- 213 sidor
- Bandtyp
- Inbunden
- Mått
- 227 x 300 mm Ryggbredd 24 mm
- Vikt
- 1308 g
- Språk
- Svenska
- Baksidestext
- Valhall är en komisk äventyrsserie som berättar om myterna om de fornnordiska asagudarna. Den har bland annat jämförts med Asterix.Som ingen annan serie är de tidigare albumen ständigt efterfrågade. Några av dem har till och med sålts för över 1000 kronor på Tradera. Äventyren i denna femte volym har, liksom äventyren i volym fyra, inte samlats tidigare.Sedan våren 2011 ges stora härliga samlingsvolymer ut. Böckerna samlar de klassiska äventyren tre och tre tillsammans med cirka 50 sidor extramaterial.Valhall: Den samlade sagan 5 är den andra volymen av 5. Denna volym innehåller äventyren:13: Balladen om Balder
14: Muren
15: Völvans syner
9789187877353 -
 Inrikes enhetsfrakt Sverige: 62 SEK
Inrikes enhetsfrakt Sverige: 62 SEK- ISBN
- 9789155264086
- Titel
- Det förtrollade kruset
- Författare
- Bøe, Sissel
- Förlag
- Bokförlaget Semic
- Utgivningsår
- 2017
- Omfång
- 30 sidor
- Bandtyp
- Inbunden
- Mått
- 201 x 267 mm Ryggbredd 9 mm
- Vikt
- 318 g
- Språk
- Svenska
- Baksidestext
- När fullmånen lyser på natthimlen samlar trollfar Grumse alla trollbarnen i sin skattkammare. Nu är det bråttom att få ut alla dyrbarheterna för att de ska samla kraft i månljuset. Viktigast av allt är det förtrollade kruset – trollfars käraste ägodel.Men Truls har haft en dröm om trollkruset och anar oråd. Och när skatten ska samlas in är kruset … försvunnet!Trollskogen är en sagolik serie böcker för de minsta, fylld med humor, dramatik och värme. Truls och Trulsa tumlar runt i skogen och råkar ut för det ena äventyret efter det andra. Varje uppslag är illustrerat med levande och detaljrika bilder av Peter Madsen, känd från sin egen succéserie Valhall.
Bokförlaget Semic 9789155264086 -

Människor och makter i vikingarnas värld
Inbunden bok. Stockholm : Ordfront. 1998. 224 sidor.
Mycket gott skick. Skyddsomslag i mycket gott skick.
Inrikes enhetsfrakt Sverige: 62 SEK- ISBN
- 9789173245913
- Titel
- Människor och makter i vikingarnas värld
- Författare
- Steinsland, Gro - Meulengracht Sørensen, Preben - Hultgård, Anders - Sjöström, Hans O.
- Förlag
- Stockholm : Ordfront
- Utgivningsår
- 1998
- Språk
- Svenska
Stockholm : Ordfront 9789173245913 -

Barkbåde
Häftad bok. Roskilde : Vikingeskibshallen. 1981. 80 sidor.
Mycket gott skick. Fint exemplar. Pärmen har lättare hanteringsspår och ett par veck. Inlagan i mycket gott skick. På danska.
Inrikes enhetsfrakt Sverige: 62 SEK- ISBN
- 9788785180025
- Titel
- Barkbåde
- Författare
- Hansen, Keld - Skamby Madsen, Jan
- Förlag
- Roskilde : Vikingeskibshallen
- Utgivningsår
- 1981
- Språk
- Danish
Roskilde : Vikingeskibshallen 9788785180025 -

Coco chanel
Inbunden bok. Bokförlaget Forum. 1993.
Mycket gott skick. Skyddsomslag i mycket gott skick.
Inrikes enhetsfrakt Sverige: 62 SEK- ISBN
- 9789137099934
- Titel
- Coco chanel
- Författare
- Madsen, Axel - Eklöf, Margareta
- Förlag
- Bokförlaget Forum
- Utgivningsår
- 1993
- Bandtyp
- Inbunden
- Vikt
- 925 g
- Språk
- Svenska
Bokförlaget Forum 9789137099934 -

Sot och slott. Levande 1700-tal vid uppländsk...
Gott skick. Svenska Turistföreningen, 1943, Hft, sid. 210-237. Extrakt ur Svenska Turistföreningens årsskrift 1943. Rikt illustrerad med svartvita fotografier och teckningar. I bra skick. … läs mer
Inrikes enhetsfrakt Sverige: 62 SEK -
![Människosonen : berättelsen om Jesus : [serieroman]](https://dez1v4fbcawql.cloudfront.net/product_thumb/2626/14421201/68487c0286a9e.jpg)
Människosonen : berättelsen om Jesus : [serie...
Tidning, tidskrift. Stockholm : Bonnier Carlsen. 1 uppl. 1995.
Mycket gott skick. Köp hur många böcker du vill från mig och betala endast för en frakt.
(Gäller vid ett och samma köptillfälle.)
Klicka på mitt namn nedan för att se alla mina böcker. … läs merInrikes enhetsfrakt Sverige: 62 SEK- ISBN
- 9789163804717
- Titel
- Människosonen : berättelsen om Jesus : [serieroman]
- Författare
- Madsen, Peter - Gahrton, Måns
- Förlag
- Stockholm : Bonnier Carlsen
- Utgivningsår
- 1995
- Språk
- Svenska
Stockholm : Bonnier Carlsen 1 9789163804717 -

Habits of the heart: Individualism and commit...
Häftad bok. University of California Press. 1996. 355 sidor.
Mycket gott skick. Blekt rygg.
Meanwhile, the authors' antidote to the American sickness—a quest for democratic community that draws on our diverse civic and religious traditions—has contributed to a vigorous scholarly and popular debate. Attention has been focused on fo läs mer … läs merInrikes enhetsfrakt Sverige: 62 SEK- ISBN
- 9780520205680
- Titel
- Habits of the heart - individualism and commitment in American life
- Utgivningsår
- 1996
- Bandtyp
- Paperback
- Språk
- English
University of California Press 9780520205680 -

I sagans land - den stora boken våra bästa kl...
Inbunden bok.
Gott skick. Bokförlaget Semic. [2018]. 156 s. Förlagsband. 20 x 26,5cm. Pärmen har ett stött hörn samt lätt ytslitage bak. Inlagan i nära nyskick förutom ett blad som hundöra.. Rikt illustrerad. … läs mer
Inrikes enhetsfrakt Sverige: 62 SEK- ISBN
- 9789155265717
- Titel
- I sagans land – den stora boken : våra bästa klassiska sagor i samlingsvolym
- Författare
- Madsen, Peter
- Förlag
- Bokförlaget Semic
- Utgivningsår
- 2018
- Omfång
- 156 sidor
- Bandtyp
- Inbunden
- Mått
- 203 x 267 mm Ryggbredd 16 mm
- Vikt
- 726 g
- Språk
- Svenska
- Baksidestext
- Här har vi samlat det bästa ur sagosuccén I sagans lands första och andra bok. Du kan hitta förtrollande berättelser för både äldre och yngre läsare och lyssnare. Spännande historier om dumsluga jättar och troll, listiga rävar och modiga prinsar och prinsessor som ger sig ut på äventyr. Möt Snövit och de sju dvärgarna, Mästerkatten, Hans och Greta i pepparkakshuset, Askungen och Rödluvan. Men också en isbjörnsprins, en tapper liten skräddare och en pojke som vill lära sig att bli rädd.Peter Madsen återberättar de klassiska sagorna i ord och bild. Det vackra och medryckande sättet att illustrera på kan bland annat kännas igen från hans tecknade serie Valhall och de populära bilderböckerna om Trollskogen.
9789155265717 -

Trollskogen: Allra bästa vänner
Inbunden bok. Bokförlaget Semic. 2018. 32 sidor.
Nyskick. Trolltvillingarna Truls och Trulsa är nästan alltid tillsammans. I varandras sällskap kan de klara av nästan vad som helst! Men så börjar Truls tvivla på att han är Trulsas bästa vän, och då går det snart riktigt galet ?
Trollskogen är en sagolik serie läs mer … läs merInrikes enhetsfrakt Sverige: 62 SEK- ISBN
- 9789155264550
- Titel
- Allra bästa vänner
- Författare
- Madsen, Peter
- Förlag
- Bokförlaget Semic
- Utgivningsår
- 2018
- Omfång
- 32 sidor
- Bandtyp
- Inbunden
- Mått
- 206 x 268 mm Ryggbredd 9 mm
- Vikt
- 311 g
- Språk
- Svenska
- Baksidestext
- Trolltvillingarna Truls och Trulsa är nästan alltid tillsammans. I varandras sällskap kan de klara av nästan vad som helst! Men så börjar Truls tvivla på att han är Trulsas bästa vän, och då går det snart riktigt galet …Trollskogen är en sagolik serie böcker för de minsta, fylld med humor, dramatik och värme. Truls och Trulsa tumlar runt i skogen och råkar ut för det ena äventyret efter det andra. Varje uppslag är illustrerat med levande och detaljrika bilder av Peter Madsen, känd från sin egen succéserie Valhall.
Bokförlaget Semic 9789155264550 -

Trollskogen Truls nya vän
Inbunden bok. Bokförlaget Semic. 2021. 32 sidor.
Nyskick. Förlagsny och helt oöppnad.
Underbara teckningar av Peter Madsen som är som små konstverk.
Litet format.
Hylla barn1Inrikes enhetsfrakt Sverige: 62 SEK- ISBN
- 9789155270025
- Titel
- Truls nya vän
- Författare
- Madsen, Peter
- Förlag
- Bokförlaget Semic
- Utgivningsår
- 2021
- Omfång
- 32 sidor
- Bandtyp
- Inbunden
- Mått
- 157 x 157 mm Ryggbredd 5 mm
- Vikt
- 137 g
- Språk
- Svenska
- Baksidestext
- Nu finns den magiska bilderboksserien Trollskogen i en lite mindre storlek för de yngre barnen. Läs om Truls, Trulsa och alla de andra trollungarnas äventyr under den stora eken i skogen.Truls är på jakt efter en ny vän. Men det är inte helt lätt! Igelkotten har för vassa taggar och snigeln är för långsam. Kanske vill haren eller fjärilen vara Truls vän?Böckerna är skrivna av Sissel Bøe och tecknade av den folkkäre illustratören Peter Madsen.
Bokförlaget Semic 9789155270025 -

Fönix
Grafik, karta. 1972.
Nyskick. Grafiskt blad lito 45/58 Signerad. tryckt av Ivan Fakkin Köpenhamn (Präglad stämpel) 75x55 cm. Dekorativ för inramning.
Inrikes enhetsfrakt Sverige: 62 SEK -

I sagans land : 12 älskade klassiska folksago...
Inbunden bok. Bokförlaget Semic. 2016. 101 sidor.
Nära nyskick. Detta är andra boken om Sagans land med bl.a. Rödluvan, Rangel-Erik med fiolen och Fiskaren och hans fru.
12 st sagor med fantstiska färgteckningar från sagornas värld utav tecknaren Peter Madsen (känd från Valhalla och Truls och Trulsa i Trollskogen).
läs mer … läs merInrikes enhetsfrakt Sverige: 62 SEK- ISBN
- 9789155262174
- Titel
- I sagans land : älskade klassiska folksagor och äventyr tecknade och berättade av Peter Madsen
- Författare
- Madsen, Peter
- Förlag
- Bokförlaget Semic
- Utgivningsår
- 2016
- Omfång
- 101 sidor
- Bandtyp
- Inbunden
- Mått
- 201 x 267 mm Ryggbredd 12 mm
- Vikt
- 532 g
- Språk
- Svenska
- Baksidestext
- Glänta på dörren till den sovande prinsessan Törnrosa, ge dig ut på jakt efter trollets gömda hjärta och möt pojken som ville lära sig bli rädd. Slå följe med den fiolspelande Rangel-Erik, Mästerkatten, Rödluvan eller lyckobarnet – men se upp för de hungriga vargar och dumsluga troll som du kan stöta på längs vägen.I den hyllade första delen av Peter Madsens sagosamling I sagans land tolkade han några av våra mest omtyckta sagor i ord och bild. Här finns ännu fler hisnande historier och glittrande guldkorn för läsare och lyssnare i alla åldrar. Njut av de underbara illustrationerna, vars stil bland annat känns igen från den tecknade serien Valhall och bilderböckerna om Truls och Trulsa i Trollskogen.
Bokförlaget Semic 9789155262174 -

Sverige från ovan
Inbunden bok. Trevi. 1 uppl. 1972. 239 sidor.
Mycket gott skick. Skyddsomslag i gott skick. Konstläderband. Skyddsomslaget något solblekt på ryggen och med viss nötning. Stort format, 24 x 24 cm.
Rikt illustrerad med flygfoton i färg och korta texter. … läs merInrikes enhetsfrakt Sverige: 62 SEKTrevi 1 -
 Inrikes enhetsfrakt Sverige: 62 SEK
Inrikes enhetsfrakt Sverige: 62 SEK- ISBN
- 9789155262099
- Titel
- Sov gott, lilla troll!
- Författare
- Bøe, Sissel
- Förlag
- Bokförlaget Semic
- Utgivningsår
- 2016
- Omfång
- 32 sidor
- Bandtyp
- Inbunden
- Mått
- 202 x 268 mm Ryggbredd 9 mm
- Vikt
- 321 g
- Språk
- Svenska
- Baksidestext
- När trollmor har sjungit för trollungarna och snott ihop deras svansar somnar de en efter en i den stora sängen. Alla utom Truls. Det spritter i hans ben och han tycker att det är urtrist att ligga vaken helt ensam när de andra sover. Och så hör han så konstiga ljud. Vad är det som låter? Åskar det? Eller är det människorna som smyger utanför Trollkullen? Trollskogen är en sagolik serie böcker för de minsta, fylld med humor, dramatik och värme. Truls och Trulsa tumlar runt i skogen och råkar ut för det ena äventyret efter det andra. Varje uppslag är illustrerat med levande och detaljrika bilder av Peter Madsen, bekant från sin egen succéserie Valhall.
Bokförlaget Semic 9789155262099 -
 Inrikes enhetsfrakt Sverige: 62 SEK
Inrikes enhetsfrakt Sverige: 62 SEK- ISBN
- 9789155260156
- Titel
- Björnen sover
- Författare
- Bøe, Sissel
- Förlag
- Bokförlaget Semic
- Utgivningsår
- 2014
- Omfång
- 32 sidor
- Bandtyp
- Inbunden
- Mått
- 200 x 267 mm Ryggbredd 8 mm
- Vikt
- 319 g
- Språk
- Svenska
- Baksidestext
- En stor björn har byggt ett ide mitt i Trollskogen. Nu ligger han där och sover och Truls och Trulsa vågar inte längre gå ut. Tänk om de måste stanna inne hela vintern! Trollfar Grumse förklarar att de inte behöver vara rädda så länge de låter björnen vara ifred. Men Trollungarna har andra planer. Med spadar och lurar i högsta hugg beger de sig mot idet … Trollskogen är en sagolik serie böcker för de minsta, fylld med humor, dramatik och värme. Truls och Trulsa tumlar runt i skogen och råkar ut för det ena äventyret efter det andra. Varje uppslag är illustrerat med levande och detaljrika bilder av Peter Madsen, bekant från sin egen succéserie Valhall.
Bokförlaget Semic 9789155260156 -
Hopdragssömmar
Häftad bok. Ica-förlaget. 3 uppl. 1968. 82 sidor.
Gott skick. Några mindre fläckar på omslagets baksida, inlagan i fint skick.
Inrikes enhetsfrakt Sverige: 62 SEKIca-förlaget 3 -
 Inrikes enhetsfrakt Sverige: 62 SEK
Inrikes enhetsfrakt Sverige: 62 SEK- ISBN
- 9789186048167
- Titel
- Valhall : den samlade sagan 1
- Författare
- Madsen, Peter
- Förlag
- Ekholm & Tegebjer förlag
- Utgivningsår
- 2010
- Omfång
- 213 sidor
- Bandtyp
- Inbunden
- Mått
- 226 x 301 mm Ryggbredd 24 mm
- Vikt
- 500 g
- Språk
- Svenska
- Baksidestext
- Valhall är en komisk äventyrsserie som berättar myterna om de fornnordiska asagudarna. Totalt består den av femton äventyr, som tidigare publicerats mellan 1979–2010.
De tidigare albumen är ständigt efterfrågade. Nu behöver läsarna inte vänta längre.
Våren 2011 startade utgivningen av stora härliga volymer som samlar de klassiska äventyren tre och tre tillsammans med 50 sidor extramaterial.
Denna första samling innehåller albumen Ulven är lös; Tors brudfärd och Odens vad. Dessutom presenteras även serien om “Ragnar och Kraka”. En berättelse som spinner vidare på en bihistoria i Odens vad. Tidigare opublicerad i seriesammanhang.
Pressröster om Valhall:
“den mest inflytelserika Eddatolkningen på åtminstone 100 år”
ÖSTGÖTACORRESPONDENTEN
“ är i sanning ett mästerverk med en storartad berättelse, härliga figurer och fantastiska bilder”
SEKVENTIELLT.SE
“Återigen har ( ) Peter Madsen lyckats med att foga ihop de delvis fragmentariska, ett årtusende gamla myterna till en levande berättelse med inre logik”
BILD & BUBBLA
Översättare: Mikael Tegebjer, Mikael Males
Ekholm & Tegebjer förlag 9789186048167 -
 Inrikes enhetsfrakt Sverige: 62 SEK
Inrikes enhetsfrakt Sverige: 62 SEK- ISBN
- 9789187877322
- Titel
- Valhall : den samlade sagan 2
- Författare
- Madsen, Peter
- Förlag
- Apart Förlag AB
- Utgivningsår
- 2015
- Omfång
- 193 sidor
- Bandtyp
- Inbunden
- Mått
- 227 x 300 mm Ryggbredd 24 mm
- Vikt
- 1235 g
- Språk
- Svenska
- Baksidestext
- Till Utgård och hem - Rackarungen Quark ställde till med oreda hos jättarna i Utgård redan i det andra Valhall-äventyret. Snart skulle han skapa kaos även hos gudarna. Men en film kom emellan och Quark fick vara med i den nordiska publiksuccén Valhall. För många människor har Valhall blivit det första mötet med den nordiska mytologin. Och så är det än i dag …Valhall: Den samlade sagan presenterar äventyren en gång för alla. Dessutom innehåller böckerna en hel del extramaterial. I denna volym samlas många hittills opublicerade förstudier till filmen Valhall samt en serie om konsten att göra tecknad film. Mellan äventyren skildras även de ursprungliga myterna och deras väg till den tecknade serien. Allt presenterat med fina illustrationer, alternativa omslag, affischer, studier och skisser … massor av skisser!Valhall: Den samlade sagan 2 är den andra volymen av 5. Denna volym innehåller äventyren:4: Historien om Quark
5: Resan till Utgårdaloke
6: De gyllene äpplena
Apart Förlag AB 2 9789187877322 -

Valhall : den samlade sagan 3
Inbunden bok. Ekholm & Tegebjer förlags. 2012. 189 sidor.
Hyggligt skick.
Inrikes enhetsfrakt Sverige: 62 SEK- ISBN
- 9789186048235
- Titel
- Valhall : den samlade sagan 3
- Författare
- Madsen, Peter
- Förlag
- Ekholm & Tegebjer förlags
- Utgivningsår
- 2012
- Omfång
- 189 sidor
- Bandtyp
- Inbunden
- Mått
- 227 x 300 mm Ryggbredd 24 mm
- Vikt
- 1260 g
- Språk
- Svenska
- Baksidestext
- Omistliga böcker för barn och ungdom, enligt Svenska Dagbladet
Valhall är en komisk äventyrsserie som berättar om myterna om de fornnordiska asagudarna. Den har bland annat jämförts med Asterix.
Sedan våren 2011 ges stora härliga samlingsvolymer ut. Böckerna samlar de klassiska äventyren – i nyöversättning – tre och tre tillsammans med cirka 50 sidor extramaterial, där arbetet bakom serien presenteras och de ursprungliga myterna återges. Denna tredje volym innehåller äventyren Ormen i djupet, Frejas smycke och Den stora utmaningen.
Pressröster
”… är i sanning ett mästerverk med en storartad berättelse, härliga figurer och fantastiska bilder”
SEKVENTIELLT.SE
”Boken är en gedigen och tilltalande produkt som verkligen förhöjs av extramaterialet.”
SVENSKA DAGBLADET
”Återigen har (…) Peter Madsen lyckats med att foga ihop de delvis fragmentariska, ett årtusende gamla myterna till en levande berättelse med inre logik”
BILD & BUBBLA
Ekholm & Tegebjer förlags 9789186048235
Your country and preferred language.
Select your country Select languageDenna webbplats använder cookies för att säkerställa att du får den bästa upplevelsen.
Stäng
Välkommen till Sveriges största bokhandel
Här finns så gott som allt som givits ut på den svenska bokmarknaden under de senaste hundra åren.
- Handla mot faktura och öppet köp i 21 dagar
- Oavsett vikt och antal artiklar handlar du till enhetsfrakt från samma säljare i samma kundvagn















![Människosonen : berättelsen om Jesus : [serieroman]](https://dez1v4fbcawql.cloudfront.net/product/864451/6384867/58a9d0ad241e1.jpg)
